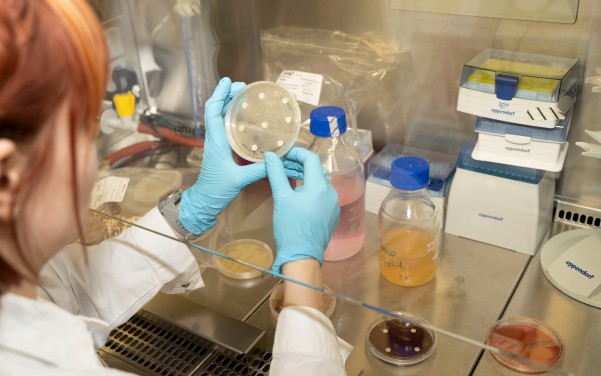

Ion Torrent:
- Ion GeneStudio S5 Prime (mit automatisierter Sequencing Preparation mittels Ion Chef-System)
- Genexus System
Bei der Short-read Sequenzierung werden kurze DNA-Fragmente, in der Regel im Größenbereich zwischen 50 und 300 Basen, sequenziert. Diese Methode wird sowohl im Bereich der Whole-Genome-Sequenzierung, als auch für die Sequenzierung bestimmter Zielregionen im Genom eingesetzt. In unserem Labor setzen wir auf das Verfahren der Halbleitersequenzierung (Ion Torrent).
Nanopore Sequenzierung:
- GridION
- MinION
Sanger Sequenzierung:
- SeqStudio
Bei der Long-read Sequenzierung können deutlich längere DNA-Fragmente gegenüber der Short-read Sequenzierung sequenziert werden. Dies kann beispielsweise bei der Detektion von komplexeren strukturellen genetischen Varianten einen Vorteil darstellen. Mit dem Verfahren der Nanopore Sequenzierung können DNA-Stränge mit einer Länge von mehreren Hundert Kilobasen sequenziert werden. Sanger Sequenzierung gilt als Goldstandard der Sequenzierungstechniken und ermöglicht eine hohe Genauigkeit besonders bei der Bestimmung einzelner Basenpaare und Mutationen.
Polymerasekettenreaktion (PCR):
- ProFlex PCR
Quantitative PCR (qPCR):
- QuantStudio 3 Real-time PCR
- QuantStudio 7 Pro Real-time PCR
Digitale PCR (dPCR):
- QuantStudio 3D Digital PCR
- QuantStudio Absolute Q Digital PCR
Aus unserm Laboralltag nicht wegzudenken und spätestens seit SARS-CoV-2 in der breiten Bevölkerung bekannt: Die Polymerasekettenreaktion, kurz PCR. Die Vervielfältigung bestimmter DNA-Zielsequenzen ist unter anderem notwendig für die anschließende Sequenzierung dieser.
Mittels qPCR können eine oder wahlweise mehrere Zielsequenzen vervielfältigt und deren Konzentration via Fluoreszensmessung quantifiziert werden. Als besondere Form der quantitativen PCR führen wir die digitale PCR durch: Diese ermöglicht eine hohe Genauigkeit durch absolute Quantifizierung.
Konfokales Laser-Scanning-Mikroskop (CLSM):
- Leica Stellaris 5
Bioreaktoren:
- BioFlo 120
Durchflusszytometrie:
- CytoFLEX
Multimode-Mikroplatten-Reader:
- TECAN spark
Inkubator
Neben der Vielzahl an molekularbiologischen Methoden führen wir auch „klassische“ mikrobiologische Methoden durch. Hierzu zählen unter anderem die Gewinnung von Reinkulturen aus Umweltproben, Wachstumsversuche von Kulturen, z.B. unter dem Einfluss von Antiobiotika oder die Bestimmung der Zellzahl mittels Durchflusszytometrie.
Unsere Bioreaktoren erlauben uns die Durchführung verschiedenster Fermentationsversuche, sowohl als Batch, Fed-Batch oder kontinuierlichem Prozess.
Automatisierte Hochdurchsatz-Extraktion:
- KingFisher DuoPrime
- KingFisher APEX
Kryostat:
- Leica CM3050 S Kryostat
verschiedene Zentrifugen
Ultrazentrifuge
Probenvorbereitung
Verschiedene Fragestellungen benötigen individuelle Probeaufbereitungs-Techniken: Wir verfügen über eine Vielzahl von Zentrifugen zur Aufkonzentration von Proben sowie einer Ultrazentrifuge zur Partikeltrennung. Für eine effiziente Extraktion von DNA und RNA stehen mehrere Hochdurchsatz-Extraktionsgeräte bereit. Unser Kryostat erlaubt uns die Anfertigung von Dünnschnitten, beispielsweise zur Untersuchung von Biofilmen.
Automatisierte Liquid-Handling Systeme:
- Hamilton ML Prep
- Hamilton MicroLab STAR
Automatisiertes Liquid-Handling
Unsere beiden automatisierten Liquid Handling Systeme unterstützen unsere Arbeit gleich in zweierlei Hinsicht: Die deutliche Zeitersparnis ermöglicht uns einen höheren Probendurchsatz bei gleichzeitig hoher Präzision.
DNA-Größenselektion:
- BluePippin Instrument
Automatisierte Elektrophorese:
- 4150 TapeStation System
Gelektrophorese
Fluorometrische Nukleinsäurequantifizierung:
- Qubit Flex Fluorometer
Neben der klassischen Gelelektrophorese zur Größenbestimmung von DNA-Fragmenten besitzen wir in unserem Labor die Möglichkeit zur Durchführung einer automatisierten Elektrophorese. Diese ermöglicht uns sowohl die Größen- als auch Konzentrationsbestimmung von DNA und RNA innerhalb weniger Minuten. Durch die Größenselektion können wir DNA-Fragmente entsprechend für die nachfolgenden Analyseverfahren auswählen.
Inkubator
Sterilbank
Autoklav
Unser Labor besitzt selbstverständlich sämtliches nötiges Equipment um mikro- und molekularbiologische Arbeiten sicher durchzuführen und qualitativ hochwertige Ergebnisse zu generieren: Sterilbänke, zum sicheren und kontaminationsfreien Arbeiten, einem Autoklaven zur Sterilisation von Verbrauchs- und Arbeitsmaterial und Flüssigmedium, sowie Ultratiefkühlgeräte zur sicheren Lagerung von Proben, DNA und RNA.